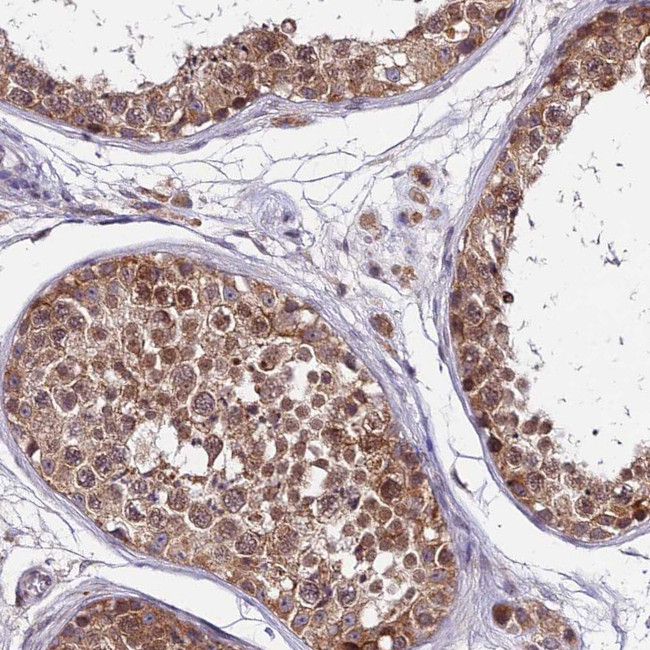
CDNF Antibody in Immunohistochemistry (Paraffin) (IHC (P))

Search
Invitrogen
CDNF Polyclonal Antibody
{{$productOrderCtrl.translations['antibody.pdp.commerceCard.promotion.promotions']}}
{{$productOrderCtrl.translations['antibody.pdp.commerceCard.promotion.viewpromo']}}
{{$productOrderCtrl.translations['antibody.pdp.commerceCard.promotion.promocode']}}: {{promo.promoCode}} {{promo.promoTitle}} {{promo.promoDescription}}. {{$productOrderCtrl.translations['antibody.pdp.commerceCard.promotion.learnmore']}}





Please note: We are reviewing Western blot images included in the antibody testing data in our catalog, including those provided by third parties. Unless expressly labeled or annotated as “raw-unedited”, Western blot images included in the antibody testing data in our catalog may have been edited, optimized or otherwise adjusted for presentation.
产品信息
PA5-60764
种属反应
宿主/亚型
分类
类型
抗原
偶联物
形式
浓度
规格
纯化类型
保存液
内含物
保存条件
运输条件
RRID
产品详细信息
Immunogen sequence: TLDLASVDLR KMRVAELKQI LHSWGEECRA CAEKTDYVNL IQELAPKYAA TH
Highest antigen sequence identity to the following orthologs: Mouse - 81%, Rat - 85%.
靶标信息
The conserved dopamine neurotrophic factor (CDNF) is a neurotrophic factor for dopaminergic neurons and highly homologous to the mesencephalic-astrocyte-derived neuro-trophic factor. Somewhat surprisingly, CDCF is expressed at higher levels in tissues such as heart, skeletal muscle and testes than in brain. Similar to the glial cell line-derived neurotrophic factor (GDNF), CDNF can prevent the 6-hydroxylamine (6 OHDA) induced degeneration of dopaminergic neurons in a rat model of Parkinsons disease. Furthermore, CDNF was able to restore the dopaminergic function and prevent the degeneration of dopaminergic neurons in the substantia nigra, suggesting that CDNF might be suitable for the treatment of Parkinsons disease. At least two isoforms of CDNF are known to exist.
仅用于科研。不用于诊断过程。未经明确授权不得转售。
篇参考文献 (0)
生物信息学
蛋白别名: ARMET-like protein 1; Cerebral dopamine neurotrophic factor; Conserved dopamine neurotrophic factor
基因别名: ARMETL1; CDNF
Entrez Gene ID: (Human) 441549